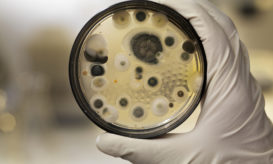
μύκητες

Φαγούρα στην ευαίσθητη περιοχή: Ποιες είναι οι αιτίες και πώς να την αντιμετωπίσετε
Αν έχετε έντονη φαγούρα στην ευαίσθητη περιοχή, οι αιτίες μπορεί να είναι από μία μυκητιασική λοίμωξη μέχρι αλλεργία σε...

Αν έχετε έντονη φαγούρα στην ευαίσθητη περιοχή, οι αιτίες μπορεί να είναι από μία μυκητιασική λοίμωξη μέχρι αλλεργία σε...

Σύμφωνα με τους επιστήμονες, τα περισσότερα μυκητιασικά παθογόνα είναι ήδη ανθεκτικά ή αποκτούν ταχύτατα αντοχή στα αντιμυκητιασικά φάρμακα
Οι ιογενείς λοιμώξεις, όπως η γρίπη και η COVID-19 αυξάνουν τον κίνδυνο διεισδυτικών λοιμώξεων.

Το μανικιούρ με σκόνη (dipping powder manicure) έχει γίνει πολύ δημοφιλές τα τελευταία χρόνια, αλλά αν δείτε τι έπαθε...